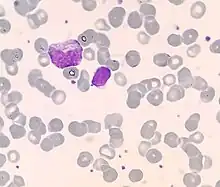

Mielocito
Los mielocitos son células inmaduras del subconjunto de los glóbulos blancos fagocíticos del sistema inmunitario. Se crean y residen en la médula ósea, aunque, debido a algunas anomalías, se pueden encontrar en la sangre.

Situación
Dentro del sistema inmunológico, encontramos las células nacientes en la médula ósea y las que nacen en el sistema linfático, como los linfocitos. Dentro de la primera opción, la médula ósea, encontramos al mieloide progenitor que dará lugar a los mielocitos. Los mielocitos son células inmaduras pertenecientes a los llamados glóbulos blancos. Los mielocitos, dentro del proceso de la hematopoyesis, irán adquiriendo la madurez y definiéndose como distintas células fagocíticas. Estas células maduras podrán ser neutrófilos, basófilos, eosinófilos o monocitos que, a su vez, den lugar a las células dentríticas y a los macrófagos.
Histología
Para ver los mielocitos deberemos usar colorantes especiales para poder teñir los glóbulos blancos. De este modo, e identificados los mielocitos, observaremos que su citoplasma es claramente basofilítico y relativamente más abundante que en los mieloblastos o los promielocitos, a pesar de que los mielocitos son células más pequeñas.
Numerosos gránulos citoplasmáticos están presentes en las formas más maduras de mielocitos. Los gránulos neutrófilos y eosinofílicos son positivos a la peroxidasa, mientras que los gránulos basófilos no lo son.
La cromatina nuclear es más gruesa que la observada en el mielocito, pero está relativamente débilmente manchada y carece de una membrana bien definida.
El núcleo es bastante regular en contorno (no indentado), y parece estar "enterrado" bajo los numerosos gránulos citoplasmáticos. (Si el núcleo estuviera sangrado, probablemente sería un metamielocito.)
Maduración
Los mielocitos se derivan de los promielocitos y dan lugar a metamielocitos. Los promielocitos son los que darán origen a los diferentes mielocitos y, éstos, a su vez, madurarán en metamielocitos. Durante este proceso llamado hematopoyésis, se irán definiendo según el tipo de célula en el que se vayan a transformar: basófilos, eosinófilos, neutrófilos o monocitos. Es importante decir que estas células son granulocitas, ya que, en su citoplasma, podemos encontrar gránulos específicos, lo cual las disferencia de las agranulocitas, como los linfocitos.
Referencias
Bibliografía
- Histology image:01810loa from Vaughan, Deborah (2002). A Learning System in Histology: CD-ROM and Guide. Oxford University Press. ISBN 978-0195151732.
- Neutrophilic Myelocyte (enlace roto disponible en Internet Archive; véase el historial, la primera versión y la última). Presented by the University of Virginia
- Eosinophilic Myelocyte (enlace roto disponible en Internet Archive; véase el historial, la primera versión y la última). Presented by the University of Virginia
- Los neutrófilos: qué son y como actúan (enlace roto disponible en Internet Archive; véase el historial, la primera versión y la última). Artículo científico publicado en La Voz de Marbella (2017)